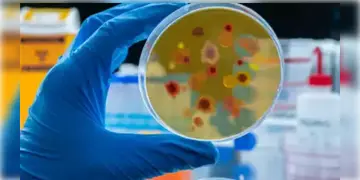

ভাইরাস সম্পর্কিত খবর | Virus News Updates in Bengali

H1N1 Virus | মাত্র ৩ মাসেই আক্রান্ত ৫১৬ মৃত্যু ৬ জনের! নতুন করে চিন্তা বাড়াচ্ছে H1N1 ভাইরাস!
Jammu-Kashmir | জ্বর, মাথা ব্যথা, বমিভাব-তারপরেই মৃত্যু! অজানা রোগে জম্মু কাশ্মীরে প্রাণ হারালেন ১৭ জন!

HMPV | 'আতঙ্কিত হওয়ার কিছু নেই..প্রতি বছরই ঘটে'! HMPV ভাইরাস নিয়ে স্বস্তির বার্তা দিলেন WHOর মুখপাত্র

HMPV | চিনে গত ১০ দিনে HMPV আক্রান্তের সংখ্যা বেড়েছে ৫২৯ শতাংশ! আতঙ্কে বন্ধ করে দেওয়া হলো স্কুল

HMPV | গুজরাট,তামিলনাড়ু, কর্নাটকের পর মহারাষ্ট্রেও ছড়িয়ে পড়লো HMPV! কতজন আক্রন্ত পশ্চিমবঙ্গে?

ICMR-NIRBI | উদ্বেগ ছড়াচ্ছে HMPV, পথ দেখাবে বাংলায় তৈরী ভারতের প্রথম ‘জীবাণু সংক্রমণ গবেষণা সংস্থার’ হাব

HMPV | কলকাতায় HMPV আক্রান্ত ৫ মাসের শিশু! ভর্তি করা হয় PICUতে! তবে দিন কয়েকের মধ্যেই সুস্থ হয়ে বাড়ি ফেরে সে

HMPV | একজন নয়, HMPVতে আক্রান্ত ভারতের দুটি শিশু! কারোরই নেই বিদেশ ভ্রমণের ইতিহাস! কীভাবে শরীরে এলো চিনা ভাইরাস?

HMPV | কতটা বিপজ্জক HMVP? কাদের ঝুঁকি বেশি? কীভাবেই বা থাকবেন সুস্থ্য? জানুন চিকিৎসকের থেকে

Virus Missing | অস্ট্রেলিয়ার ল্যাব থেকে হারিয়ে গেলো শয়ে শয়ে মারাত্মক ভাইরাস! ফের কি বিশ্বে ছড়াবে মহামারী?

Bleeding Eye Virus | ৫ দিনের মধ্যে ইন্টারন্যাল হ্যামারেজ, ৭ দিনের মধ্যে মৃত্যু! আতঙ্কের নয়া নাম ব্লিডিং আই ভাইরাস

Antimicrobial Resistance । ২০৫০ সালের মধ্যেই ৪ কোটি মানুষের মৃত্যু হবে ‘অ্যান্টিমাইক্রোবিয়াল রেজিস্ট্যান্স’ নামক রোগে

Nipah Virus | কেরলে নিপা ভাইরাসের আতঙ্ক! মাস্ক পরার নির্দেশ কেরলের স্বাস্থ্যমন্ত্রী!

Gujarat Chandipura Virus । নয়া ভাইরাস 'চাঁদিপুরা'র প্রকোপে গুজরাটে মৃত্যু ৬ শিশুর! ‘অ্যালার্ট মোডে’ স্বাস্থ্যদফতর!

CCHF । উকুনজাতীয় পরজীবীর মাধ্যমে পড়শী দেশে ছড়িয়ে পড়ছে ভয়াবহ ভাইরাস!এখনও পর্যন্ত এই রোগের নেই কোনও টিকা!

Bird Flu | ভারতের চারটি রাজ্যে ভয়াবহ আকার নিচ্ছে H5N1 ভাইরাস! ফ্লু প্রতিরক্ষার জন্য বিশেষ পরামর্শ দিলেন বিজ্ঞানীরা!

Nipah Virus News | কেরলের নিপা ভাইরাস কলকাতায়! নিপা ভাইরাস আক্রান্ত সন্দেহে হাসপাতালে ভর্তি যুবক! জানুন এই ভাইরাসের উপসর্গ কী কী?

Nipah Virus News | সংক্রমণের হার কম হলেও মৃত্যুহার বেশি! কেরলে নিপা ভাইরাসের আতঙ্কে ৭টি গ্রামকে কন্টেন্টমেন্ট জোন করলো সরকার!








